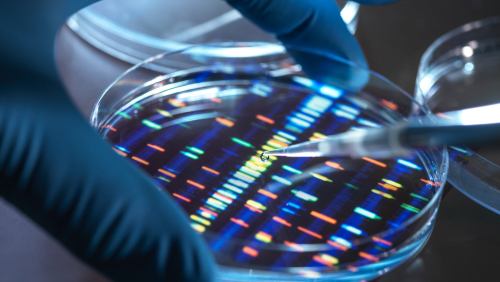

Online Presence
How to Increase Your Brand’s Exposure By Integrating These 2 Tools
Social media excels in direct communications with consumers, while PR builds brand trust and fosters lasting customer loyalty. Together, they form a powerful combination for brand success.